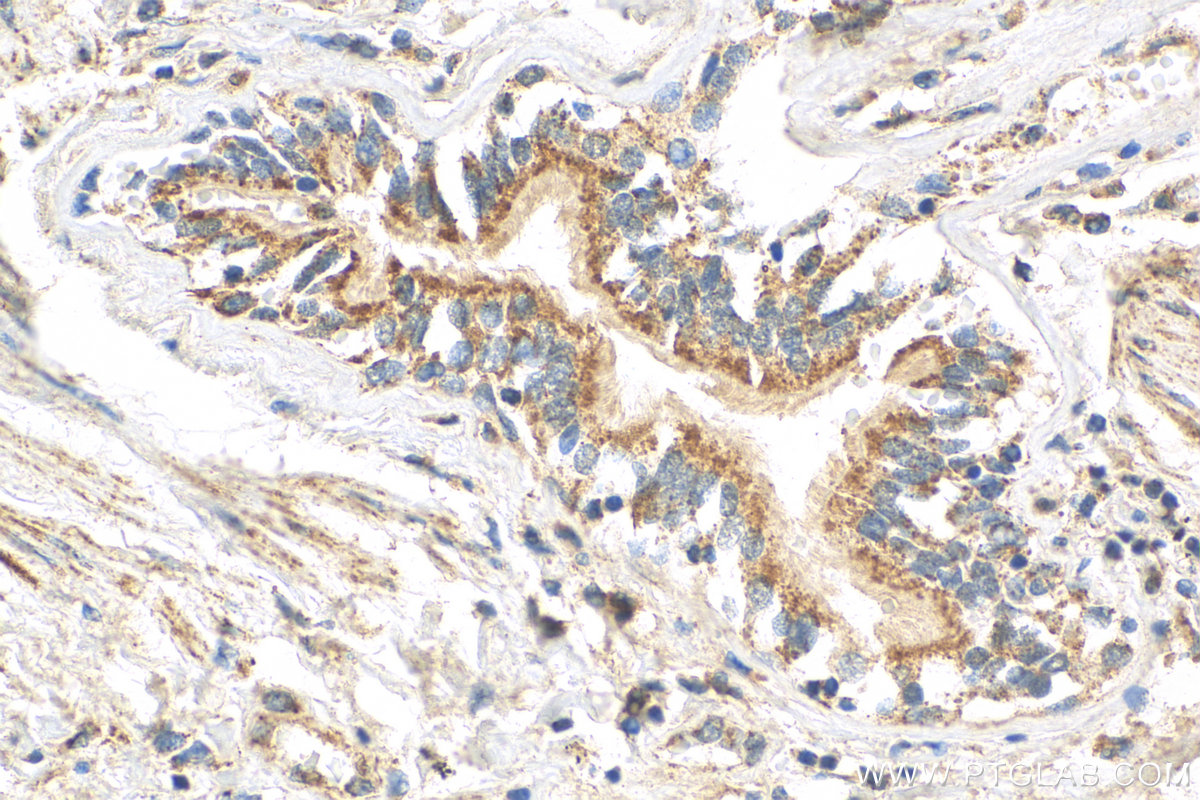

验证数据展示
经过测试的应用
| Positive WB detected in | HT-29 cells, RAW 264.7 cells, Sp2/0 cells |
| Positive IHC detected in | human placenta tissue, human lung tissue, mouse lung tissue Note: suggested antigen retrieval with TE buffer pH 9.0; (*) Alternatively, antigen retrieval may be performed with citrate buffer pH 6.0 |
| Positive IF/ICC detected in | THP-1 cells |
推荐稀释比
| 应用 | 推荐稀释比 |
|---|---|
| Western Blot (WB) | WB : 1:1000-1:6000 |
| Immunohistochemistry (IHC) | IHC : 1:50-1:500 |
| Immunofluorescence (IF)/ICC | IF/ICC : 1:50-1:500 |
| It is recommended that this reagent should be titrated in each testing system to obtain optimal results. | |
| Sample-dependent, Check data in validation data gallery. | |
产品信息
29958-1-AP targets cGAS in WB, IHC, IF/ICC, ELISA applications and shows reactivity with human, mouse samples.
| 经测试应用 | WB, IHC, IF/ICC, ELISA Application Description |
| 文献引用应用 | WB, IHC, IF |
| 经测试反应性 | human, mouse |
| 文献引用反应性 | human, mouse, rat |
| 免疫原 |
CatNo: Ag31677 Product name: Recombinant mouse cGAS protein Source: e coli.-derived, PET28a Tag: 6*His Domain: 350-507 aa of BC145651 Sequence: KNAKDGNSFQGETWRLSFSHTEKYILNNHGIEKTCCESSGAKCCRKECLKLMKYLLEQLKKEFQELDAFCSYHVKTAIFHMWTQDPQDSQWDPRNLSSCFDKLLAFFLECLRTEKLDHYFIPKFNLFSQELIDRKSKEFLSKKIEYERNNGFPIFDKL 种属同源性预测 |
| 宿主/亚型 | Rabbit / IgG |
| 抗体类别 | Polyclonal |
| 产品类型 | Antibody |
| 全称 | RIKEN cDNA E330016A19 gene |
| 别名 | m cGAS, Mb21d1, mcGAS, m-cGAS |
| 计算分子量 | 58 kDa |
| 观测分子量 | 58 kDa |
| GenBank蛋白编号 | BC145651 |
| 基因名称 | cGAS |
| Gene ID (NCBI) | 214763 |
| RRID | AB_2935491 |
| 偶联类型 | Unconjugated |
| 形式 | Liquid |
| 纯化方式 | Antigen affinity purification |
| UNIPROT ID | Q8C6L5 |
| 储存缓冲液 | PBS with 0.02% sodium azide and 50% glycerol, pH 7.3. |
| 储存条件 | Store at -20°C. Stable for one year after shipment. Aliquoting is unnecessary for -20oC storage. |
背景介绍
cGAS (cyclic GMP-AMP synthase) is a cytosolic DNA sensor that serves to mount an immune response against the invasion of microbial pathogens such as viruses. cGAS normally resides as an inactive protein in the cell. Upon binding to DNA, cGAS undergoes a conformational change to an active state and produces the second messenger cyclic GMP-AMP (cGAMP) from ATP and GTP, which is subsequently detected by the cyclic-dinucleotide sensor STING, an ~40 kDa dimeric transmembrane protein at the endoplasmic reticulum (ER). cGAS not only is found in the cytosol but has a multifaceted cellular distribution that involves localization at the cell membrane and in the nucleus (PMID: 32424334). The calculated molecular weight of cGAS is 58 kDa. With post-translational modification, the MW of cGAS will be migrated to 70 kDa.
实验方案
| Product Specific Protocols | |
|---|---|
| WB protocol for cGAS antibody 29958-1-AP | Download protocol |
| IHC protocol for cGAS antibody 29958-1-AP | Download protocol |
| IF protocol for cGAS antibody 29958-1-AP | Download protocol |
| Standard Protocols | |
|---|---|
| Click here to view our Standard Protocols |
发表文章
| Species | Application | Title |
|---|---|---|
Adv Sci (Weinh) Hierarchical Targeting Nanodrug with Holistic DNA Protection for Effective Treatment of Acute Kidney Injury | ||
J Adv Res TRPM2-mediated feed-forward loop promotes chondrocyte damage in osteoarthritis via calcium-cGAS-STING-NF-κB pathway | ||
Cell Rep Exercise-induced adipokine Nrg4 alleviates MASLD by disrupting hepatic cGAS-STING signaling
| ||
Respir Res YAP/TAZ-mediated nuclear membrane rupture in promoting senescence of skeletal muscle associated with COPD | ||
Naunyn Schmiedebergs Arch Pharmacol Decursin protects against DSS-induced experimental colitis in mice by inhibiting the cGAS-STING signaling pathway | ||
Food Chem Toxicol Triptolide exposure triggers ovarian inflammation by activating cGAS-STING pathway and decrease oocyte quality in mouse |